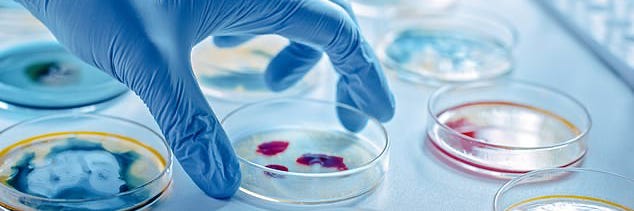

C&C. Peaceful Fire. Virus Won’t Leak. Food Inflation. IA Resists.
May 7 | Posted by mrossol | Biden, Childers, Democrat Party, DOJ, Health, Pushing Back, Transparency[non], US ConstitutionMedia ignores Portland attacks; Chinese scientists editing Ebola DNA to make it easier to transmit; corporate media freakout over fast food inflation; and Iowa joins Texas against Biden; and more.
Source: FIERY LESSONS ☙ Tuesday, May 7, 2024 ☙ C&C NEWS
WORLD NEWS AND COMMENTARY
🔥🔥 Oh, Portland. This morning’s top story comes from the Times of Israel, since U.S. media found the story too obscure to publish. The Times’ headline yesterday read, “Portland pro-Palestinian group claims it torched 17 cop cars.” First off, torching a fleet of cop cars is NOT domestic terrorism. That label is reserved for Christians protesting abortion clinics. And sane people:
As the image above shows, apparently Portland’s anarchistic Antifa groups have their own website and a blog. Porlanders, try to follow me here, but you can use the website to find the criminals.
Anyway, according to the manifesto claiming responsibility, Antifa, who was so very active during the 2020 Summer of Protest supporting black folks, has unfolded a different section of its utility knives, and now supports radical religious jihadi muslims in Palestine. Not everyday Palestinians, mind you. They like the terrorist ones. Not only that, they claimed their attack supported native Americans and black folks and students and even anarchical heroes of history. Here’s what the “Rose City Brigade” said in its statement:
On May Day we torched some PPB cars at their training facility. We cut through a fence, set ten fires and are happy it grew to burn fifteen cars!
Our attack was preemptive. We knew the occupation at Portland State U. would be swept violently and wanted to attack the police before.
Above all we did it for the Palestinian martyrs! We did it for the Haymarket Martyrs (ed. note: the Haymarket Martyrs are eight bombmaking anarchists arrested in Chicago in 1886). We did it for all the Black and Indigenous rebels murdered by slavers and settlers.
We did it for all the brutalized student protesters.
Makes sense. I mean, if you’re going to burn up a whole fleet of police cars, you might as well pile in as many different groups as you can. Portland’s anarchists did, stretching all the way back to 1886 to find comrades to share in the sweet anti-cop glory.
The putatively untraceable May 2nd website post (no arrests have been made) went on to provide a lengthy list of suggestions for student protestors, about how to make their pro-Palestine protests even more violent. “If the cops come,” the Rose City Anarchists encouraged students, “don’t just resist arrest, fight them!” It relied on simple logic: “They will hate you and beat you if you’re peaceful or violent, and it is time to be violent!”
As a lawyer, I should pause at this point to suggest students should consider ignoring Antifa’s advice, and cooperating when confronted with tense, anxious law enforcement officers authorized to use deadly force to uphold the law. Especially when you act violent.
But I’m not sure what the Antifans were worrying about in any case. The students, the Portland Library Free Palestine Occupation Operation (PLF-POO), taught the Millar University Library a lesson it won’t soon forget:
Sadly, students have lost access to their library, which is closed for the remainder of the year, boarded up. But the protest violence against school property has had an effect, turning the tide: a spokesvehicle for the surviving Portland police car fleet said it gives up, it will accede to the anarchists’ demands as soon as it can figure out what the they are.
It’s been a week since the preemptive po-po burning. Local Fox-12 reported this weekend that cleanup efforts were underway after three days of mostly-peaceful protests at Portland State University, its library, and nearby businesses. The protests are now over. They’ve re-opened Portland U.’s campus. Except for the library. Which wants to let the protestors know it is very sorry and please don’t occupy it again.
💉💉 Yesterday, the UK Daily Mail ran a face-palming story under the wildly suggestive headline, “Chinese scientists create mutant Ebola virus to skirt around biosafety rules – and it causes horrific symptoms and kills group of hamsters. The furry rodents were, obviously, hardest hit. But don’t get so worked up about it; after all, what could go wrong?
Well, according to the Mail’s article, one thing could go wrong. The Mail primly informed readers about appallingly terrific recent lab-leak statistics:
Data released this March revealed that lab leak incidents occur every year and included the release of controlled pathogens like tuberculosis and anthrax. There are anywhere from 70 to 100 releases were recorded every year.
Seventy to a hundred leaks? A year? Well, that’s not exactly reassuring. We are all unwillingly playing a viral version of Russian Roulette.
In contrast to the perhaps-slightly-overheated-headline, the article explained that the experiment was actually intended to come up with a “safer” Ebola variant. Remember, good intentions are the most important thing. Currently, Ebola may only be handled in Biosafety Level 4 (BSL-4) facilities with special high security features like airlocks and space suits. Which can be inconvenient if you want to play with Ebola a lot. So, they tinkered with Ebola’s genes, for convenience and for safety, so that Ebola can be safely handled at lower BLS-2 security settings, which are comparable to a regular dentist’s office.
Specifically, scientists combined a cow stomach virus (vesicular stomatitis virus), with the part of Ebola virus DNA that helps the virus enter and infect host cells. Then they inflicted their new Frankenstein virus on a very unlucky batch of three week-old hamsters. All the female hamsters died horribly. All but two of the male hamsters died.
Success! The researchers concluded their new virus makes hamsters very sick.
The Mail quoted random expert Dr. Richard Ebright, a chemical biologist at Rutgers University in New Jersey totally unconnected to the project, apparently an ‘expert’ since he has a degree in something, who was optimistic. Dr. Ebright, who definitely trusts the science, was skeptical that any lab leak could lead to a widespread mutant Ebola infection in the general public.
He firmly believes that the scientists will do the right thing. Dr. Ebright professorially advised, “It will be imperative to verify that the novel chimeric virus does not pose risk of infectivity, transmissibility, and pathogenicity in humans, before proceeding with studies at biosafety level 2.”
Sure, good point. It would clearly be illegal to experiment on Ebola variants that could infect humans at BSL-2 levels. But … Dr. Ebright elided right over the main point: what about a lab leak from a BSL-4 lab? I realize that the whole covid thing, which probably came from the Wuhan, China BSL-4 lab, is an outlier, but come on. We literally all just lived through this scenario.
Oh well. Covid wasn’t enough of a lesson .I suppose they’ll keep on doing this until it backfires badly somewhere. We are living in an age of biological revolution, among several other types of technological revolutions, and during the revolutionary process you may experience some discomfort, as the doctors like to say.
Finally, I hate to leave you with this question, but if these are the kinds of experiments that we know about, that they cheerfully discuss right in the journals, what kinds of viral tinkering are they doing in secret?
📈 Two weeks ago, the New York Times ran an eyebrow-raising article under the heavily ironic headline, “With Inflation This High, Nobody Knows What a Dollar Is Worth.” Certainly the New York Times doesn’t know what a dollar is worth, and hasn’t for a long time. Joe Biden might not know, either. “Wages keep going up, and inflation keeps coming down,” Biden boasted in January, during his State of the Union address.
But independent researchers, using what they call the “Fast Food Index,” claim otherwise. Since last week, a viral image has been widely making the rounds. It caught my attention this morning, because I noticed that it stung corporate media, which immediately rushed to put out the political fires.
Here’s the viral graphic, which conclusively proves the real scale of inflation at a glance:
But wait! Don’t believe your lying eyes! Among several other platforms, all simultaneously late last week, CNBC’s political fire brigades rushed out the Biden Administration’s talking-points fire truck:
CNBC was clearly uncomfortable putting much in writing. Instead its article referred readers to a “video explainer.” CNBC’s cheerful, MTV-style video explainer argued that you just shouldn’t use fast food as any kind of barometer for inflation. But the video couldn’t carry it off. First off, CNBC schizophrenically used the government’s figures as a starting point; the Consumer Price Index (CPI) grudgingly admits only that fast food is up +23% since Biden took office.
But then, blowing up its own argument in mid-sentence, in the video CNBC used a Subway turkey sub as an example. The sub cost $5 two years ago. It costs $11 now. Even Portlanders can tell that’s a lot more than +23%.
Laughably, trying to find the bright side, CNBC claimed the higher prices were leading to higher profits and benefiting investors. But this week’s headlines tell a completely different story:
Two days ago, the Wall Street Journal ran a related story headlined, “Consumers Fed Up With Food Costs Are Ditching Big Brands.” The article described alert Laguna Niguel consumer Denis Montenaro, 75, who recently ran by McDonald’s to grab his favorite order: a bacon and egg bagel and a black coffee. The retired manager “was stunned to see the $9.67 bill.”
That’s it! “I’m done with fast food,” Montenaro told the Journal.
Basically, and tying right to Biden’s ridiculous SOTU claim, CNBC dutifully explained how fast food price inflation is really good news. “After the pandemic,” CNBC patiently lectured, “employers competed with each other to hire employees, by offering higher wages.” So increased labor cost is the main reason, according to CNBC, that food prices are skyrocketing.
See? It’s good news — for employees, that is, whose paychecks are getting bigger. Or is it? CNBC stopped short of imaging how those employees receiving higher wages then have to turn right around and buy higher-priced food items. So they aren’t really getting a raise. They might even be going backwards. But I digress.
The desperate, sold-out, government-captured, corporate media propaganda platform then hawked even more “good news”: CNBC assured viewers that inflation is stabilizing now, so you don’t need to worry about that $11 sub costing $22 dollars by the end of the year. Of course, they’ve been claiming that inflation was stabilizing ever since Biden first infested the White House, but don’t hold that against them.
They’re right, this time. If not, they’ll have another complicated explanation for why not.
This almost seems like a cliche, but if a Republican were occupying the White House, inflation would be all that CNBC would be talking about, twenty-four-by-seven, and not in this good, optimistic, seeing-the-bright-side way. It would be the End of the Financial World. Trust me.
This video article, and the other similar ones, is a terrific example of one of the media’s favorite psyops, which they usually deploy in a series of articles. This time, that one viral graphic panicked them and they combined all the stages into one article. Here’s the formula: (1) It isn’t actually happening. (2) It might be happening sometimes but it’s very rare. (3) You should be happy that it’s happening.
🔥 Finally, in great news from Iowa, the Epoch Times reported that, like Texas, the Hawkeye state and its governor Kim Reynolds have thrown down the gauntlet late last week against Biden’s illegal immigration schemes:
Governor Reynolds signed a new immigration law on April 10th, and last week said the state would start enforcing it in July. “The only reason we had to pass this law is because the Biden administration refuses to enforce the laws already on the books,” she told Epoch Times on Thursday.
Under the new criminal law, Iowa authorities can arrest any person with outstanding deportation orders, who was previously removed from the United States, or who was previously denied admission to Iowa.
Last month, the Biden Administration gave Governor Reynolds until today, May 7th, to agree she will not enforce the new law, or else the federal government will sue Iowa, arguing the state’s new law is unconstitutional, since the power to regulate immigration is reserved to the federal government, not the states.
Progressive activist group Iowa Migrant Movement for Justice said on Facebook the law “perpetuates partisan campaign rhetoric, drives fear in immigrant communities, and mobilizes voters using fear and anti-immigrant sentiment.” The group has also vowed to sue the very instant Iowa enforces the new law.
But Iowa’s law anticipated constitutional challenges, and tried to avoid those problems by tracking federal law. So the federal government’s Orwellian argument will have to be framed as the right to not enforce the law. In other words, under the doctrine of preemption, states can make similar laws but may not contradict federal law. Iowa will argue it is just tracking federal law and not contradicting it. Biden’s DOJ will argue with a straight face that Iowa’s law contradicts Biden’s deliberate choice to not enforce the immigration laws.
We need to have this argument, and decide the question of whether the states can enforce federal laws when the federal government deliberately ignores them. It’s a question the courts have resisted deciding for a long time, always previously finding procedural escape hatches and workarounds to avoid deciding this difficult states-rights question.
Isn’t it also bonkers that Iowa — located far from any U.S. border, practically in the middle of the country — must battle the federal government over illegal immigration.
Good for you, Iowans! Keep the pressure on.
Have a terrific Tuesday! And roll back here tomorrow morning in your not-burned up car, for more delicious, definitely not overpriced, Coffee & Covid.
We can’t do it without you. Consider joining with C&C to help move the nation’s needle and change minds. I could use your help getting the truth out and spreading optimism and hope, if you can: ☕ Learn How to Get Involved 🦠
How to Donate to Coffee & Covid
Twitter: jchilders98.
Truth Social: jchilders98.
MeWe: mewe.com/i/coffee_and_covid.
Telegram: t.me/coffeecovidnews
C&C Swag! www.shopcoffeeandcovid.com

Leave a Reply
You must be logged in to post a comment.